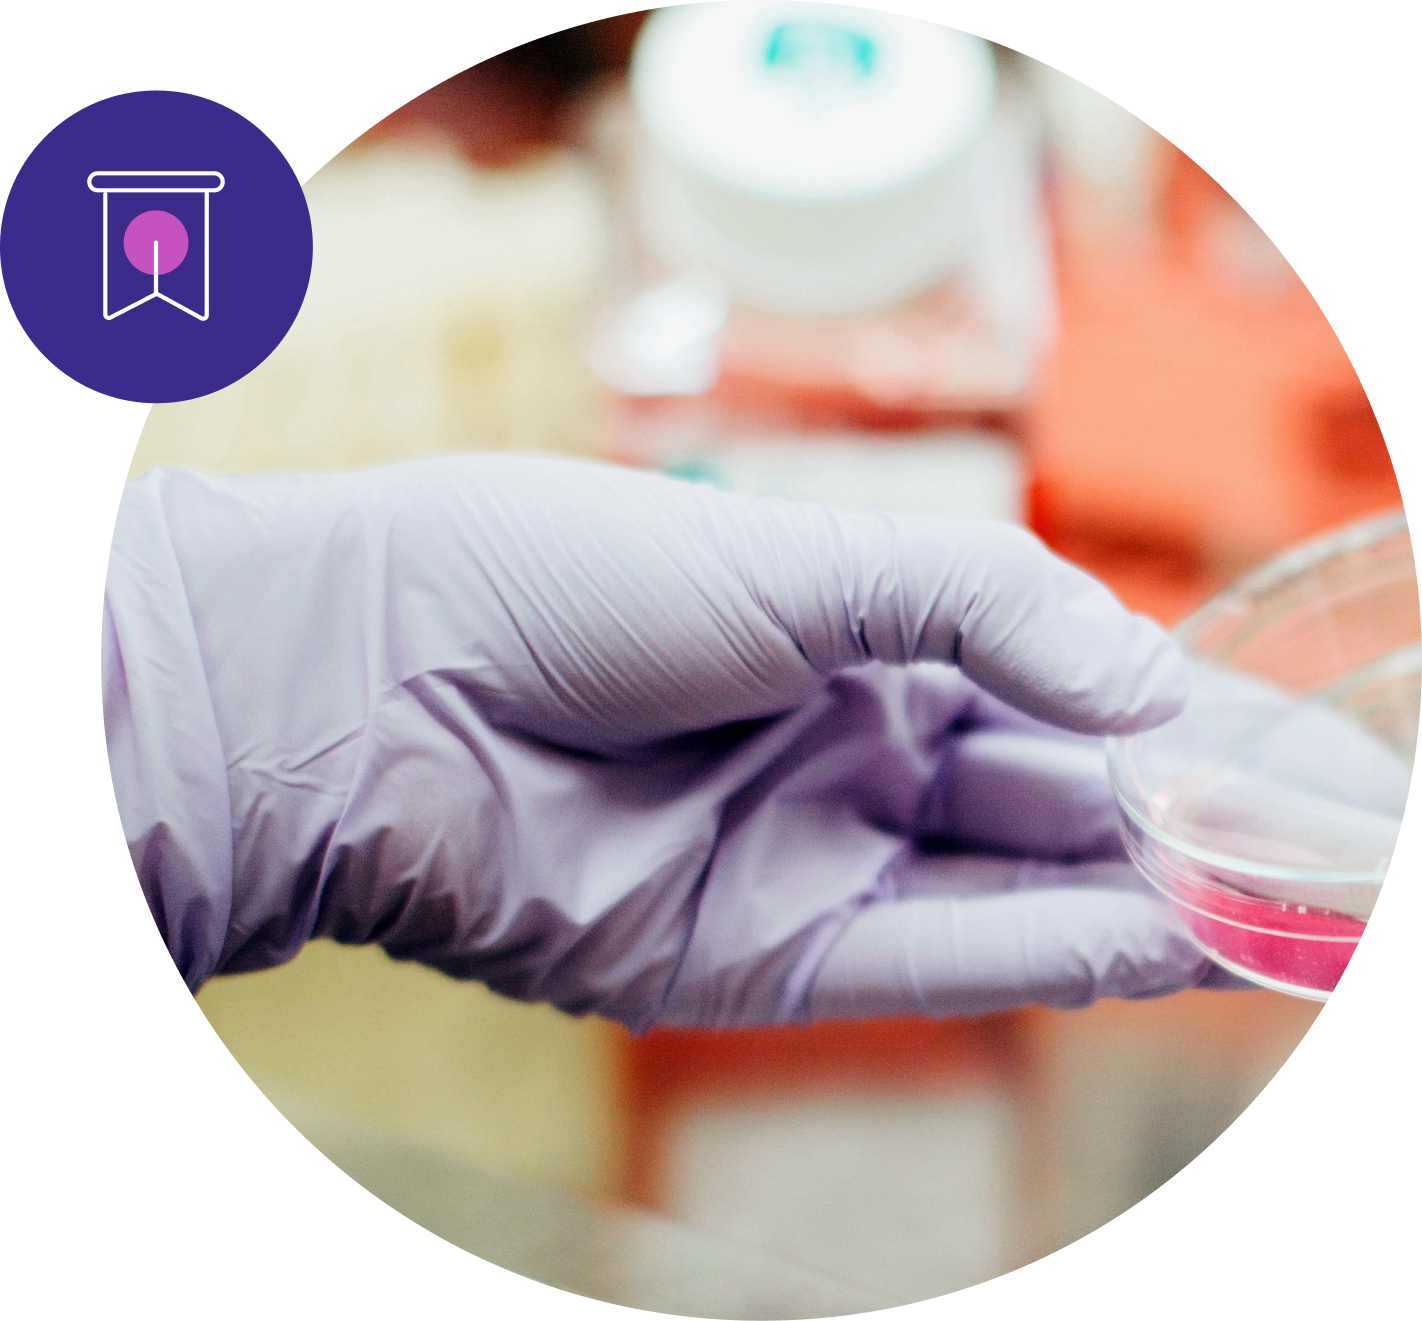

Matrix-M® Adjuvant
Enhancing Immune Response

Matrix-M is Novavax’s proprietary adjuvant, used in vaccines and vaccine candidates for a variety of diseases to help tackle some of the world’s most pressing health challenges.1
Matrix-M adjuvant contains Quillaja saponins, a group of naturally occurring chemical compounds, sustainably harvested and purified from the bark of the soapbark tree (Quillaja saponaria Molina).1
An adjuvant is a substance that helps induce a stronger, longer-lasting and broad immune response when added to a vaccine in order to enhance effectiveness.1
Matrix-M enhances the body's immune response in a targeted and efficient way significantly improving both the magnitude and duration of immune response.1

Current Matrix-M Applications and Collaborations
Matrix-M is clinically proven and is a key component in two marketed vaccines:
Key Attributes of Matrix-M
Benefits of Novavax’s proprietary Matrix-M adjuvant include:

Optimal Adjuvant Profile
Favorable efficacy, safety and tolerability profile in clinical trials1
Antigen Sparing
Reduces the cost of production because less antigen is needed for manufacture of finished products4

Broad Applicability
Has the potential to be used across a wide range of diseases
Overcoming Poor Immunogenicity
Potentially enables new vaccines to be developed for bacteria and viruses that have been historically challenging due to poor immunogenicity
Applying Matrix-M to Oncology
Novavax is currently exploring research partnerships and collaborations in immuno-oncology. We envision exciting potential opportunities for our proprietary adjuvant technology in this rapidly developing field, by helping to improve rate and duration of anti-tumor response to cancer vaccines.
Amplifying Innovation
Matrix-M, when combined with our recombinant, protein-based nanoparticles, provides the technology platform upon which all candidates in our diverse vaccine pipeline are being developed.
Learn more about our cutting-edge research and ongoing partnerships to help solve the world’s most pressing health challenges here:
- Stertman L. et al.; The Matrix-M™ adjuvant: A critical component of vaccines for the 21st century. Hum Vaccin Immunother. 2023 Dec 31;19(1):2189885. doi: 10.1080/21645515.2023.2189885.
- Keech C. et al.; Phase 1-2 trial of a SARS-CoV-2 recombinant spike protein nanoparticle vaccine. New England Journal of Medicine. 2020 Dec 10;383(24):2320-2332. doi: 10.1056/NEJMoa2026920.
- WHO recommends R21/Matrix-M vaccine for malaria prevention in updated advice on immunization. News release. World Health Organization. Oct 2, 2023. Accessed Apr 15, 2025. https://www.who.int/news/item/02-10-2023-who-recommends-r21-matrix-m-vaccine-for-malaria-prevention-in-updated-advice-on-immunization
- Reed, S., Orr, M. & Fox, C. Key roles of adjuvants in modern vaccines. Nat Med 19, 1597–1608 (2013). https://doi.org/10.1038/nm.3409